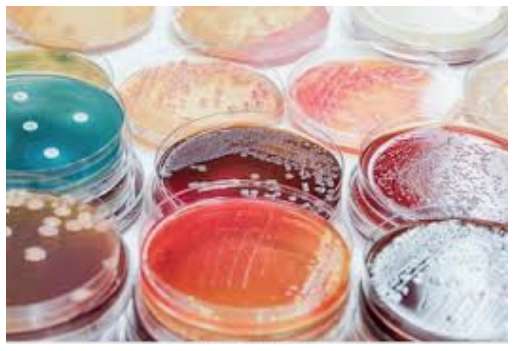

Приглашаем вас принять участие в цикле бесплатных вебинаров 16, 17, 18 и 19 июня 2020 г., посвященных современным решениям микробиологического анализа пищевой и фармацевтической продукции.
В рамках вебинаров будут рассмотрены классические ручные и автоматизированные методы проведения микробиологического анализа с целью выявления санитарно-значимых микроорганизмов с использованием современных технологий детекции ПЦР и NGS для проверки и контроля качества сырья и готовой продукции.
16 июня, вторник, время московское
Автоматизация классического микробиологического анализа
|
11.00-12.00
|
Автоматизация пробоподговки для рутинного микробиологического анализа: гомогенизаторы, дилютеры, пакеты для гомогенизации, дозаторы,
Ирина Ваннеру-Краснова, Interscience
|

|
|
12.00-13.00
|
Автоматизация посева образца на чашках Петри с EasySpiral, инкубация и подсчет колоний с ScanStation,
Ирина Ваннеру-Краснова, Interscience
|
|
13.00-14.00
|
Автоматизация приготовления питательных сред: средоварки и разливочные модули,
Ирина Строкина, ABE
|
17 июня, среда, время московское
Определение патогенов классическими методами и ПЦР
|
11.00-12.00
|
Новый формат дегидрированных сред для предобогащения образцов! Комплексное решение проведения микробиологического анализа: биохимические панели RAPID, Microbact, латексная аглютинация O.B.I.S, атмосферная генерация, ДИП-слайды Oxoid, воздухозаборники,
Мария Толкачева, Thermo FS
|

|
|
12.00-13.00
|
Определение патогенных микроорганизмов в пищевых образцах методом ПЦР в реальном времени, высокая производительность – возможность анализа до нескольких сотен проб в день, SureTect,
Мария Толкачева, Thermo FS
|

|
18 июня, четверг, время московское
Cеквенирование для определения видовой принадлежности; валидированная мойка лабораторной посуды
|
11.00-12.00
|
Проверка подлинности продуктов питания методом автоматизированного секвенирования, Ion GeneStudio S5,
Мария Толкачева, Thermo FS
|

|
|
12.00-13.00
|
Лабораторное стекло наивысшего качества по доступной цене Rasotherm и Duran,
Александер Греннер, Duran
|
|
13.00-14.00
|
Достоверная и валидируемая мойка «простой» и сложной лабораторной посуды, автоматы Miele,
Александра Данилова, Miele
|
19 июня, пятница, время московское
Микробиологический контроль на фармацевтическом производстве
|
11.00-12.00
|
Классический микробиологический анализ воды и лекарственных средств методом мембранной фильтрации,
Алексей Ельфимов, Merck (Millipore)
|

|
|
12.00-13.00
|
Испытание лекарственных препаратов на стерильность методом закрытой мембранной фильтрации Steritest, достоверные результаты,
Алексей Ельфимов, Merck (Millipore)
|
|
13.00-14.00
|
Серия автоматизированных приборов для дезинфекции поверхностей, просты в использовании, компактны и мобильны Phileas Devea,
Ирина Строкина, АВЕ
|
|